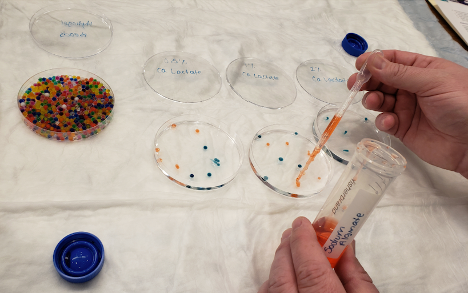

Bioengineering professor Chelsea Magin, PhD collaborated with former middle school teacher and current RTD Training Specialist Mandi Ruud Singleton and the Colorado BioScience Institute (Institute) to host a hands-on training for middle school educators.
The Institute cultivates and diversifies the state’s life sciences workforce, from classroom, to campus, to career. One of the best ways to achieve this goal is to connect teachers with immersive STEM learning opportunities. This teacher learning opportunity was offered through the Institute’s Classroom programs and supported in partnership with Medtronic Foundation providing access to high-quality STEM educational resources to reach underserved and underrepresented students across Colorado. The training hosted on the CU Anschutz Medical Campus connected 14 middle school teachers with real-world applications of hydrogels – materials that can absorb large amounts of water without dissolving. In our everyday lives these materials function as superabsorbers in diapers, as the basis for the boba in your favorite tea drink, and as the moisturizing components of single-use cosmetic face masks. Magin’s research uses hydrogels to engineer 3D models of lung tissue that enable us to study lung diseases and hopefully find new cures.

The training included an introduction to hydrogels, a tour of the Magin lab, and a hands-on activity where teachers explored making their own hydrogels. Each teacher was provided with a protocol and a kit for repeating these experiments in the classroom funded by the Medtronic Foundation. Singleton connected the concepts learned during the day with Next Generation Science Standards and Colorado Academic Standards.
“
“This understanding opens up a world of possibilities for educators seeking to inspire their students. By incorporating hydrogel experiments into the classroom, we not only teach scientific principles but also instill a sense of wonder and curiosity about the world around us. Imagine the excitement as students witness firsthand the water absorption properties of hydrogels – it’s not just a lesson; it’s a journey into the future of science and technology.”
Benjamin Prylinski 7th and 8th Grade Science Teacher, Altona Middle School
To learn more about the Colorado BioScience Institute, visit their website here.
Leave a comment